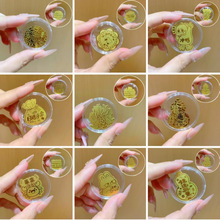
���999����Ո�lؔ�S���֙C�N����2mg�����ƬС�YƷ���l

共 6941件
甜黃金
相關產品
所有類目
-
歐美時尚超閃C圈滿鑽耳環女星星鏈條小眾設計感耳圈個性創意耳飾
-
男鍍金項鏈黃銅鍍金飾品沙金24K鏤空龍頭項鏈女源頭廠家貨源批發
-
【歌旗】金色城市寬面戒指女士開口做舊指環街頭潮流男女戒子廠家
-
S925銀針復古立體雙愛心甜酷風耳墜銅鍍18K金輕奢高級感耳釘飾品
-
正宗獼猴桃樹果苗紅心軟棗嫁接雌雄同株耐寒特大南北種植庭院果樹
-
正宗獼猴桃樹果苗紅心軟棗嫁接雌雄同株耐寒特大南北種植庭院果樹
-
台灣甜葡萄柚果樹苗黃心西柚苗嫁接雞尾葡萄柚苗黃金葡萄柚果樹苗
-
嫁接山楂苗大五棱金星山楂樹苗南方北方種植庭院盆栽地栽當年結果
-
徐香軟棗獼猴桃樹果苗嫁接紅心公母同株地栽盆栽庭院南北種植果樹
-
黃金足金999貔貅招財神獸鑰匙扣手機掛件中式商務伴手禮商務禮品
-
一件代發四季蔬菜種子南北方農家陽台盆栽種菜香菜生菜油菜原廠易
-
足金999平安喜樂考拉黃金手機掛件鑰匙扣卡通包包送朋友吊墜
-
一件代發四季蔬菜種子南北方農家陽台盆栽種菜香菜生菜油菜原廠易
-
一件代發四季蔬菜種子南北方農家陽台盆栽種菜香菜生菜油菜原廠易
-
足金999公主請發財黃金手機貼暴富2mg爆款金片小禮品批發
-
足金999黃金掛件馬到成功鑰匙扣含金包包掛飾創意禮品網紅吊墜
-
黃金草嗷嗷叫長白山野生精草正品官方旗艦店化石草男茶養生茶
-
黃金手機貼有錢花貓公主請發財暴富財庫馬上有錢財神爺足金手機貼
-
好運連連小金卡黃金手機冰箱貼金片潮流手機裝飾品足金999送禮物
-
基地直售嫁接新品種早518甜桃樹苗圃批發早熟518油桃樹苗
-
精茶黃金草嗷嗷叫化石草
-
芍葯花種根四季種植開花易活室內外庭院盆栽芍葯根塊重瓣混色大花
-
徐香軟棗獼猴桃樹果苗嫁接紅心公母同株地栽盆栽庭院南北種植果樹
-
男鍍金項鏈黃銅鍍金飾品沙金24K鏤空龍頭項鏈女源頭廠家貨源批發
-
正宗泰國山竹樹苗超甜大果無籽盤南北方種植四季栽地栽帶土帶葉發
-
爆款足金999黃金2mg手機貼暴富財庫公主請發財含金手機貼直播禮品
-
足金999金手機貼公主請發財黃暴富小掛件飾品爆款金片小禮品批發
-
轉運手機貼黃金2mg平安喜樂好運連連暴富貼片金卡引流爆款禮品
-
黃金手機貼公主請發財暴富搞錢要緊財神爺財庫足金冰箱貼禮物金貼
-
黃金店櫥窗仿足金結婚單福豬牌項鏈 批發鍍真金龍鳳婚慶新娘項鏈
-
黃金草嗷嗷叫草東北長白山正品精茶泡水喝野精草生旗艦店養生
-
新款熱賣戒指女ins風鍍18K金蛇形開口指環滿鑽小眾輕奢高級感個性
-
台灣黃金超甜葡萄柚苗正宗嫁接葡萄柚 雞尾葡萄柚果樹苗當年結果
-
長白山野生精草500g精茶化石草黃金草嗷嗷叫茶東北吉林經草
-
嫁接獼猴桃樹果苗紅心軟棗雌雄同體耐寒南北種植庭院當年結果
-
s925銀冷淡風高級感耳釘小眾設計水滴雙愛心耳墜通勤簡約氣質耳環
-
長白山野生精草嗷嗷叫東北化石草精茶黃金草正品官方旗艦店
-
黃金手機貼公主請發財暴富財庫起勢財神爺八方來財足金手機貼禮品
-
正宗獼猴桃樹果苗軟棗紅心雌雄同株嫁接南北種植盆栽地栽當年結果
-
正宗獼猴桃樹果苗紅心綠心軟棗耐寒嫁接南北四季種植雌雄同株盆栽